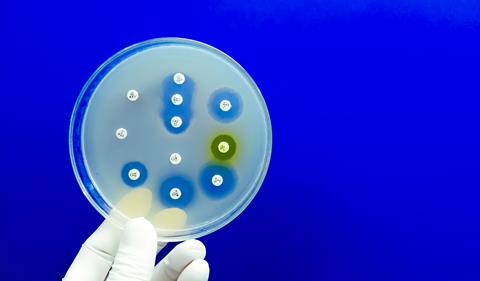
Antimicrobial,Susceptibility,Testing,In,Petri,Dish.,Antibiotic,Resistance,Of,Bacteria

Penn engineers have built an AI model that creates new antibiotics – and early tests show some work as well as existing approved drugs.
The University of Pennsylvania has developed a generative artificial intelligence (AI) model capable of designing brand new antibiotics, marking what researchers say is a major step forward in the fight against drug-resistant bacteria.
In a study published in Cell Biomaterials, engineers at Penn Engineering and colleagues across the university present AMP-Diffusion, a generative AI tool that designs antimicrobial peptides (AMPs) – short amino acid chains that kill bacteria. In animal trials, several of the AI-designed molecules worked as effectively as existing FDA-approved antibiotics and showed no detectable side effects.
For decades, scientists have warned of the looming crisis of antibiotic resistance. New drugs have proved difficult and slow to develop, leaving health systems around the world struggling to keep up. Generative AI, best known for producing images and text, could offer a radically faster approach.
Nature’s dataset is finite; with AI, we can design antibiotics evolution never tried.
“Nature’s dataset is finite; with AI, we can design antibiotics evolution never tried,” says César de la Fuente, presidential associate professor at the University of Pennsylvania, who co-led the work.
Pranam Chatterjee, assistant professor at Penn Engineering who began the project while at Duke University, adds: “We’re leveraging the same AI algorithms that generate images, but augmenting them to design potent new molecules.”
From mammoths to microbes
De la Fuente’s lab has long used AI to scour unconventional biological sources for antimicrobial properties, from the proteins of woolly mammoths to animal venoms and ancient microbes. Yet the rate at which resistance emerges has outstripped these discoveries. “Unfortunately, antibiotic resistance keeps increasing faster than we can discover new antibiotic candidates,” he says.
Chatterjee’s group, meanwhile, has focused on using AI to design peptides for hard-to-treat diseases. Their collaboration was a natural match. “It seemed like a natural fit,” says Chatterjee. “Our lab knows how to design new molecules using AI and the de la Fuente Lab knows how to identify strong antibiotic candidates using AI.”
Drug-resistant bacteria are on the rise worldwide, spreading faster than new antibiotics can be developed. The World Health Organization (WHO) calls it one of the biggest threats to global health. Credit: Saiful52/Shutterstock[/caption]
A diffusion model for medicine
While large language models such as ChatGPT predict the next word in a sequence, diffusion models generate content by starting with random noise and progressively refining it into a coherent whole. This is the principle behind creative AI systems like DALL·E and Stable Diffusion.
Instead of teaching the model the ABCs of biology, we started with a fluent speaker.
AMP-Diffusion applies the same concept to biology. Instead of denoising pixels, it shapes amino acid sequences into plausible peptides. “It’s almost like adjusting the radio,” says de la Fuente. “You start with static and then eventually the melody emerges.”
Unlike other teams that have tried diffusion models for antibiotics, Penn’s approach leans on ESM-2, a protein language model from Meta trained on hundreds of millions of sequences. By building on an existing ‘mental map’ of how proteins fit together, AMP-Diffusion generates candidates more quickly and with a higher chance of being biologically valid.
“Instead of teaching the model the ABCs of biology, we started with a fluent speaker,” says Chatterjee. “That shortcut lets us focus on designing peptides with a real shot at becoming drugs.”
From 50,000 ideas to two winners
AMP-Diffusion generated around 50,000 peptide sequences. But testing even a fraction in the lab would be impossible. To narrow the field, the researchers turned to another AI tool, APEX 1.1, developed in de la Fuente’s lab. It ranked the candidates based on predicted bacteria-killing power, novelty and diversity.
It’s exciting to see that our AI-generated molecules actually worked. This shows that generative AI can help combat antibiotic resistance.
From this, the team synthesised 46 peptides for laboratory and animal testing. In mouse models of skin infection, two molecules stood out – performing on par with levofloxacin and polymyxin B, well-established antibiotics used against resistant bacteria. Crucially, no harmful side effects were observed.
“It’s exciting to see that our AI-generated molecules actually worked,” says Chatterjee. “This shows that generative AI can help combat antibiotic resistance.”
What’s next
The researchers see this as just the beginning. AMP-Diffusion could eventually be refined to design antibiotics for specific infections or tuned to prioritise molecules with particularly desirable drug-like properties. “We’ve shown the model works and now if we can steer it to enhance beneficial drug-like properties, we can make ready-to-go therapeutics,” says Chatterjee.
For de la Fuente, the long-term ambition is radical speed. “Ultimately, our goal is to compress the antibiotic discovery timeline from years to days,” he says.
With drug resistance now listed among the top global health threats by the World Health Organization, breakthroughs like this could prove transformative.
Topics
- Amino Acids
- Antibiotics
- Antimicrobials
- Artificial Intelligence (AI)
- Assays
- Biotechnology & Bioengineering
- Computational Techniques
- Dr Pranam Chatterjee (Assistant Professor at Penn Engineering)
- Drug Discovery Processes
- Hit-to-Lead
- Microbiology
- Molecular Biology
- Penn Engineering (School of Engineering and Applied Science)
- Pennsylvania University
- Peptide Therapeutics
- Prof. César de la Fuente (University of Pennsylvania)
- Technology
- Translational Science







